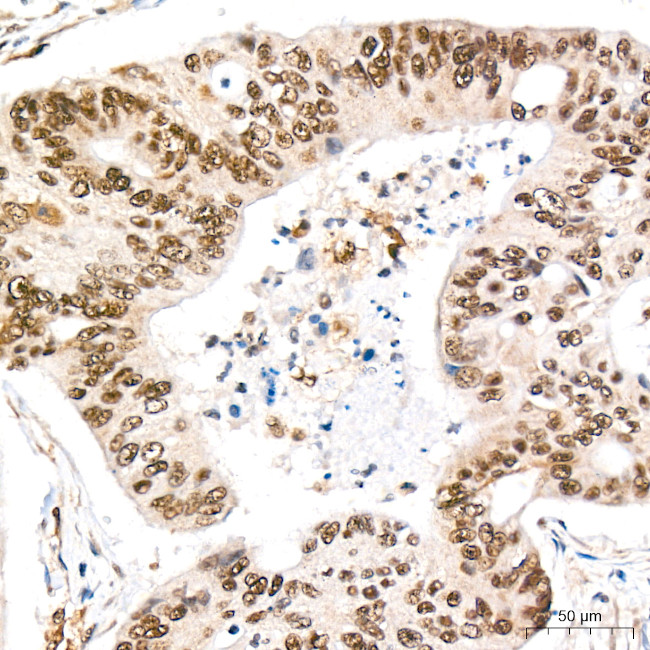
REPIN1 Antibody in Immunohistochemistry (Paraffin) (IHC (P))

Search
Invitrogen
REPIN1 Recombinant Rabbit Monoclonal Antibody (2X2E9)
{{$productOrderCtrl.translations['antibody.pdp.commerceCard.promotion.promotions']}}
{{$productOrderCtrl.translations['antibody.pdp.commerceCard.promotion.viewpromo']}}
{{$productOrderCtrl.translations['antibody.pdp.commerceCard.promotion.promocode']}}: {{promo.promoCode}} {{promo.promoTitle}} {{promo.promoDescription}}. {{$productOrderCtrl.translations['antibody.pdp.commerceCard.promotion.learnmore']}}
图: 1 / 4
REPIN1 Antibody (MA5-57992) in IHC (P)




Please note: We are reviewing Western blot images included in the antibody testing data in our catalog, including those provided by third parties. Unless expressly labeled or annotated as “raw-unedited”, Western blot images included in the antibody testing data in our catalog may have been edited, optimized or otherwise adjusted for presentation.
产品信息
MA5-57992
种属反应
宿主/亚型
Expression System
分类
类型
克隆号
抗原
偶联物
形式
浓度
规格
纯化类型
保存液
内含物
保存条件
运输条件
RRID
产品详细信息
Immunogen sequence: SCDDCGRSFR LERFLRAHQR QHTGERPFTC AECGKNFGKK THLVAHSRVH SGERPFACEE CGRRFSQGSH LAAHRRDHAP DRPFVCPDCG KAFRHKPYLA AHRRIHTGEK PYVCPDCGKA FSQKSNLVSH RRIHTGERPY ACPDCDRSFS QKSNLITHRK SHIRDGAFCC AICGQTFDDE ERLLAHQKKH DV
靶标信息
Replication initiator 1 (REPIN1) is a gene encoding a zinc-finger protein that plays a critical role in various metabolic processes. Located on chromosome 7 in humans, REPIN1 is prominently expressed in liver and adipose tissues. It is associated with the regulation of body weight and triglyceride levels, as evidenced by its locus within a quantitative trait locus (QTL) related to these metabolic traits. The REPIN1 protein is involved in enhancing DNA bending, which is crucial for replication initiation. Studies have shown that deleting REPIN1 in the liver can lead to improved insulin sensitivity and altered lipid metabolism, with secondary effects on adipose tissue. Additionally, REPIN1 is implicated in iron metabolism and apoptosis regulation, further underscoring its multifaceted role in cellular processes.
仅用于科研。不用于诊断过程。未经明确授权不得转售。
篇参考文献 (0)
生物信息学
蛋白别名: 60 kDa origin-specific DNA-binding protein; 60 kDa replication initiation region protein; ATT-binding protein; DHFR oribeta-binding protein RIP60; DNA-binding protein REPIN1; Zinc finger protein 464
基因别名: REPIN1; RIP60; ZNF464
Entrez Gene ID: (Human) 29803